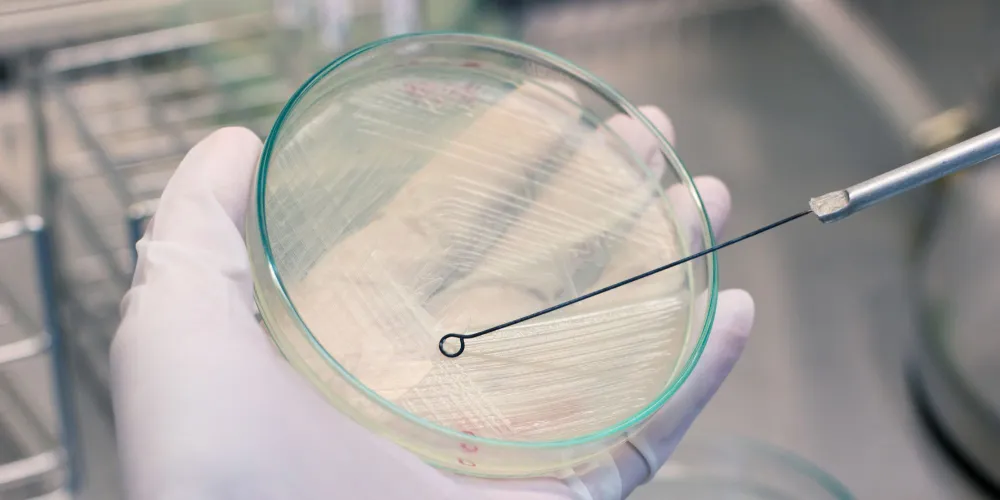

Bartın Üniversitesi (BARÜ) Lisansüstü Eğitim Enstitüsü Moleküler Biyoloji ve Genetik Ana Bilim Dalı yüksek lisans öğrencisi Buket Yıldırım’ın yürütücülüğünü yaptığı proje, Türkiye Sağlık Enstitüleri Başkanlığı (TÜSEB) A Grubu Acil Ar-Ge Proje Destek Programı kapsamında desteklenmeye değer bulundu.
BARÜ Fen Fakültesi Moleküler Biyoloji ve Genetik Bölümünden Doç. Dr. Dursun Kısa ile Biyoteknoloji Bölümünden Prof. Dr. Ayşegül Gümüş danışmanlığında geliştirilen "DHFR Hedefli Pirimidin Türevlerinin: In-Vitro – In Silico ve Transkripsiyonel Temelli Antimikrobiyal Etkilerinin Araştırılması" başlıklı projeyle enfeksiyona neden olan bakterilerin hayati fonksiyonlarını sonlandırmak için çalışmalar yapılacak.
Proje ekibi tarafından yürütülecek çalışmalarda mikrobiyal enfeksiyonları ortadan kaldırmaya yönelik farmakolojik özellikte tasarlanan 4 farklı aday bileşik sentezlenecek. Sentezlenen bu bileşiklerin ilaç olma potansiyeli farklı bilimsel analiz yöntemleriyle incelenecek.
BARÜ Rektörü Prof. Dr. Ahmet Akkaya, insan sağlığına yönelik geliştirilen ve TÜSEB tarafından desteklenen yenilikçi projelerinden dolayı yüksek lisans öğrencisi Buket Yıldırım ile proje ekibini tebrik ederek çalışmalarında başarılar diledi.
